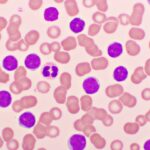
AMPLIFY Trial Reports Results of Acalabrutinib-Venetoclax in TN-CLL

AMPLIFY Trial Reports Results of Acalabrutinib-Venetoclax in TN-CLL
Acalabrutinib-venetoclax (AV) demonstrated superior progression-free survival (PFS) versus standard dosing protocols of fludarabine-cyclophosphamide-rituximab (FCR) or bendamustine-rituximab (BR) in patients with treatment-naive (TN) chronic lymphocytic...
Studies Support Zanubrutinib Treatment in CLL/SLL
Zanubrutinib monotherapy or zanubrutinib plus obinutuzumab (ZO) followed by zanubrutinib monotherapy led to high rates of overall and complete response in patients with chronic...
Trends and Issues in Fertility Preservation Among Patients with Sickle Cell Anemia
A recent multicenter study sought to elucidate trends and issues regarding fertility preservation in people undergoing treatment for sickle cell anemia. They found that...
Ketogenic Diet Boosts CAR T-Cell Therapy in Mouse Model
A study presented atthe ASH Annual Meeting indicates that β-hydroxybutyrate (BHB), the principal metabolite produced during ketosis, augmented the function of chimeric antigen receptor...